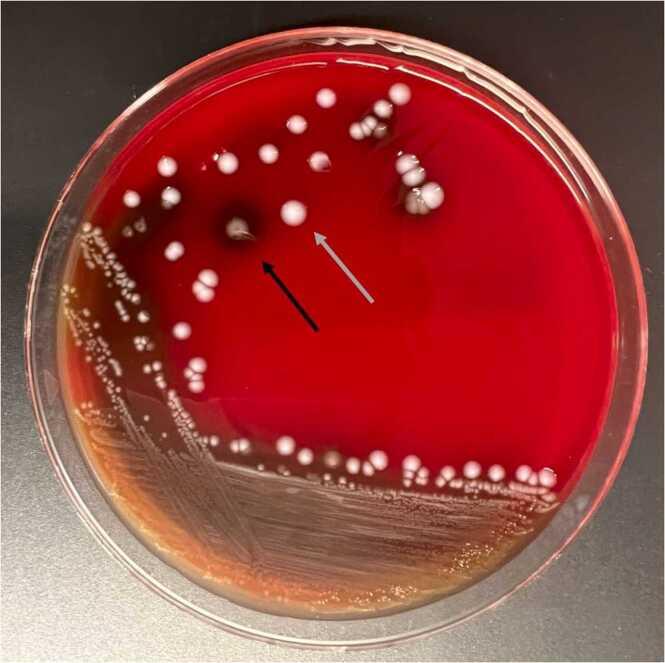

一种未得到充分认识且正在出现的抗生素耐药性感染原因。
: An under-recognized and emerging cause of antibiotic-resistant infection.
作者信息
Brunswick James, Spiro Jeffrey, Wisniewski Piotr
机构信息
Department of Internal Medicine, Naval Medical Readiness and Training Center, 34800 Bob Wilson Drive, San Diego, CA 92134, United States.
Division of Infectious Diseases, Naval Medical Readiness and Training Center, 34800 Bob Wilson Drive, San Diego, CA 92134, United States.
出版信息
IDCases. 2024 May 24;36:e01995. doi: 10.1016/j.idcr.2024.e01995. eCollection 2024.
, a bacterium generally isolated from fish and domestic animals, is a rarely reported human pathogen whose clinical characteristics and antimicrobial susceptibility remain uncertain. In this case report we describe a 19-year-old active-duty military sailor who suffered a blast injury to the left foot from a firework explosion. The injury was complicated by a polymicrobial wound infection that included . infections in humans are often associated with skin and soft tissue infection, including those resulting from trauma or blast injuries. This case serves to highlight this pathogen's role in causing invasive infections and as well as the importance of recognizing its clinical characteristics and antibiotic resistance profiles.
是一种通常从鱼类和家畜中分离出来的细菌,是一种报道较少的人类病原体,其临床特征和抗菌药敏性仍不确定。在本病例报告中,我们描述了一名19岁的现役海军水手,他因烟花爆炸导致左脚爆炸伤。该损伤并发了包括……在内的多微生物伤口感染。该细菌在人类中的感染通常与皮肤和软组织感染有关,包括由创伤或爆炸伤引起的感染。本病例旨在突出这种病原体在引起侵袭性感染中的作用,以及认识其临床特征和抗生素耐药谱的重要性。